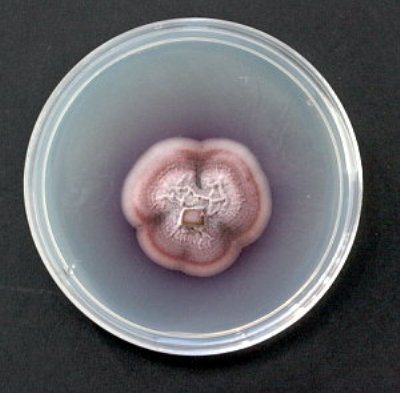

Chi l’ha detto che le auto pulite arriveranno tra decine di anni? Probabilmente sono più vicine di quello che ci aspettiamo. Da qualche anno è scattata in Europa una sorta di “gara” a chi produce più biodiesel, e l’Italia, di solito uno dei Paesi meno attenti all’ambiente, è sorprendentemente tra le prime posizioni.
Si sa che i biocarburanti non sempre sono eco-sostenibili. Se prodotti con materiali cosiddetti “food”, cioè quelli che si mettono in concorrenza con il cibo, sono controproducenti, e dunque nella maggior parte dei casi stanno venendo abbandonati. Ma ci sono diverse produzioni da materiali “no-food”, come fiori, alghe e batteri, in continua espansione sul mercato.











 Che lo si prepari con la classica caffettiera napoletana piuttosto che con le meno tradizionali moke di nuova generazione, o le caffetterie espresso e a filtro, il
Che lo si prepari con la classica caffettiera napoletana piuttosto che con le meno tradizionali moke di nuova generazione, o le caffetterie espresso e a filtro, il